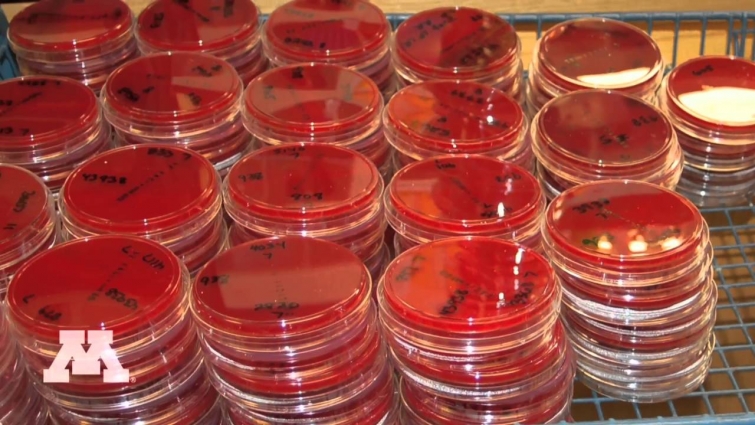
Veterinary Diagnostic Laboratory

My Client Pets #52 My Client Pets, in this series, just i am keeping and updating my client pets which are all coming for treatment regularly to laikas05 Pet Clinic, …
Category: Pet Care
5 Most Emotional Saving animal of Vietnam Animal Vet clinic
animal 5 Most Emotional Saving animal of Vietnam Animal Vet clinic Hello dear friend, We are one of the Animal vet clinic in Vietnam working to help the pets, …
English Bulldog Puppy Visits VET for the first time.. She was nervous
englishbulldogpuppy #englishbulldog #vet Follow Us On Instagram: https://www.instagram.com/cliff_k_ https://www.instagram.com/fatbulldognuggets.
SUMMERCUT FOR "SHINE" THE SHIH TZU | BEFORE DURING AND AFTER || GROOMER STYLE
SUMMERCUT FOR “SHINE” THE SHIH TZU | BEFORE DURING AND AFTER || GROOMER STYLE Welcome to my channel Guy’s Subscribe me here …
OUR DAY WITH THE VET
Mommy, AAH Miracle, also saw the vet… But unfortunately hooman lost all her original videos that she got that day when she transferred everything to her new …
Veterinary Diagnostic Laboratory
The College’s Veterinary Diagnostic Laboratory (VDL) provides outstanding specialty facilities and expertise in the diagnosis and eradication of disease.
Do Dogs and Cats Need to Have Their Teeth Brushed?
Jeanne Perrone, CVT, VTS (Dentistry) explains why it’s so important to brush a dog and cats teeth for maintaining good oral health in cats and dogs as well as …
How to Brush your dog's teeth – AKC Vet's Corner
February is National Pet Dental Health Month. Dr. Jerry Klein, Chief Veterinary Officer of the AKC explains how to maintain your dog’s dental hygiene. Brushing …
Super Easy & Healthy Home Made Dog Food Recipe – From A Past Vet Tech! Recipe #4
Homemade dog food for Jack, and Prince!! I feed my dog(s) a variety of foods. Here is a meal I made them today!
Vet Ambulance – LEGO Friends – 41086 – Product Animation
Rescue animals in the LEGO® Friends Vet Ambulance with Emma mini-doll, a hedgehog, stretcher, water bottle and a hair bow. For more LEGO® videos: …